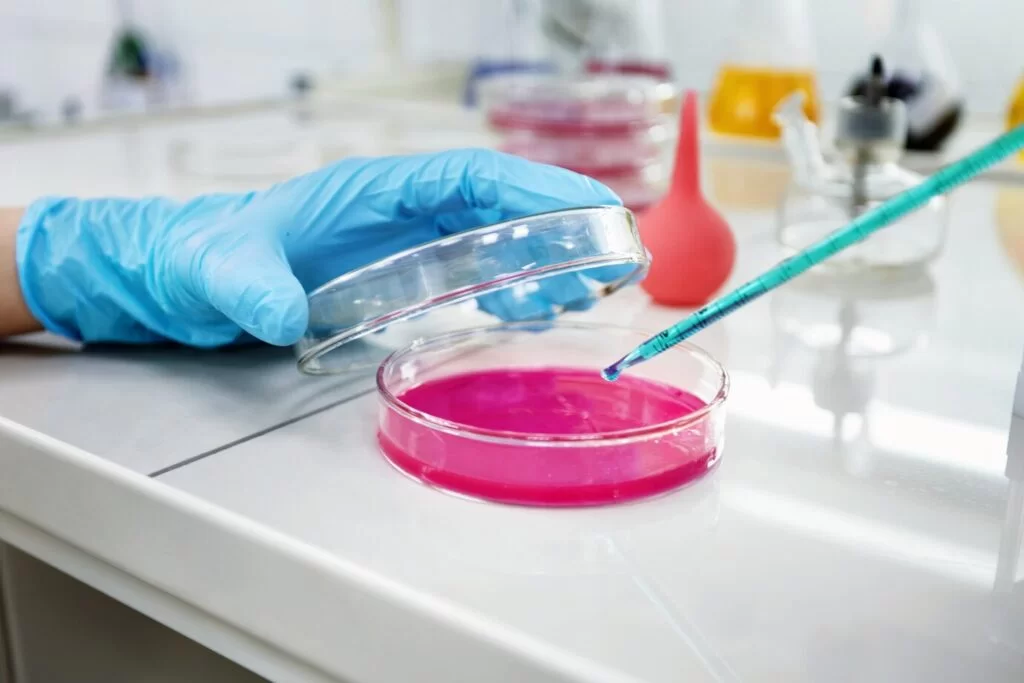

NGS Enzymes and Reagents
Next-Generation Sequencing (NGS) has revolutionized the field of life sciences, enabling rapid and efficient sequencing of DNA and RNA. Significant advancements in NGS technology have led to increased throughput, reduced costs, and improved accuracy, expanding its applications across various research areas.
Key Advances in NGS:
- Increased Throughput: NGS platforms now generate massive amounts of sequencing data in a short amount of time, allowing for deeper and more comprehensive analysis.
- Reduced Cost: The cost of NGS has decreased dramatically, making it more accessible to researchers.
- Improved Accuracy: NGS technology has become more accurate, reducing the likelihood of sequencing errors.
- Longer Read Lengths: Advances in sequencing chemistry have enabled longer read lengths, facilitating the assembly of larger and more complex genomes.
- Single-Cell Sequencing: NGS can now be used to sequence the DNA or RNA of individual cells, providing insights into cellular heterogeneity and diversity.
Krishgen offers NGS enzymes and reagents that power the high-throughput sequencing technologies used in modern genomics. These specialized enzymes, including DNA polymerases, ligases, and reverse transcriptases, along with carefully formulated buffers and adapters, ensure accurate and efficient library preparation, amplification, and sequencing of DNA or RNA samples.
Reagents offered for NGS by Krishgen Partners:
- DNA/RNA Extraction Kits
- Fragmentation Reagents
- Library Preparation Kits
- Conjugates
- Flourescence Reagents / ddNTPs

Explore NGS Reagents from AAT Bioquest
AAT Bioquest is a leading provider of life science reagents, offering a wide range of products for molecular biology research, including Next-Generation Sequencing (NGS) reagents. Their NGS reagents are designed to support various applications, from whole-genome sequencing to targeted gene sequencing. Reagents offered:
- DNA Sequencing building blocks
- Fluorescent ddNTPs

NGS Prep Kits and Enzymes from Biochain
BioChain offers a wide range of NGS reagents, including library preparation kits, enzymes, and other essential tools for next-generation sequencing research. BioChain’s SeqPure PCR purification/NGS Kits and Enzymes offer a highly cost-effective solution for library cleanup, fully compatible with all Illumina sequencing platforms
While BioChain’s RNAseq enzymes are rigorously quality-controlled for use in our kits, they are also available separately for inclusion in your own cost-effective sequencing master mixes.
Library Preparation Kits:
RapidSeq Small RNA and Directional mRNA Kits: These kits are designed for fast and cost-effective library preparation for RNA-seq applications.
KAPA Library Preparation Kits: BioChain offers several KAPA-branded library preparation kits, including the KAPA HyperPlus Library Prep Kit and the KAPA Hyper Prep Kit, which are compatible with various NGS platforms.
NGS Kits & Enzymes:
KAPA HiFi Kits: These kits feature the KAPA HiFi DNA Polymerase, which provides high-efficiency, high-fidelity amplification for NGS and PCR applications.
KAPA HyperPure Beads: These beads offer a tunable and highly consistent solution for reaction purification and size selection in NGS library construction workflows.
KAPA NGS FFPE DNA QC Kit: This kit is designed for quality control of FFPE DNA samples prior to NGS library preparation.
Features:Cost-Effective
- Efficient and Fast
- High Quality and Reliability
- Customizable Solutions
High Quality and Reliability
Versatility
Ease-of-Use
Increased Throughput
If you cannot find what you are looking for, Get in touch with our team to explore more.

